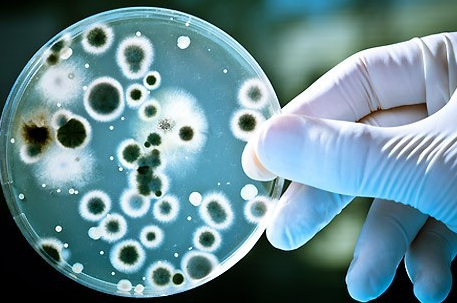

생물학자가 오랫동안 거듭 연구를 했는데도 불구하고 바로 최근에 이르기까지 단백질을 획득하는 문제는 해결되지 않았습니다. 처음에는 미생물은 고가의 음식물이나 사료(맥주의 맥아즙, 당밀, 설탕 등), 혹은 미생물을 생산하는데 기술적인 문제점이 있는 재료를 사용해서 미생물을 증식시켰는데요.

그러나 얼마 후 과학자들은 입수하기가 쉽고 가격이 저렴한 원료를 찾아내는 연구에 몰두했습니다. 그 과정에서 석유의 탄화수소를 이용하여 미생물을 증식시킨다는 아이디어가 떠오르게 되죠. 이것은 아주 탁월한 아이디어였다고 할 수 있는데요. 혹시 탄수화물의 경우처럼 석유나 그 분류물(비등점이 다른 액체 혼합물을 가열하여 비등점이 낮은 것부터 점차 높은 것으로 유출 분리시키는 조작) 중에서 세력이 좋고 잘 증식하는 미생물을 선택할 수 있다면 기상이나 기후조건에 좌우되지 않는 공장에서 사료용의 '인공 단백질'을 대량으로 생산할 수 있기 때문이었죠.
이러한 매력적인 아이디어에 많은 과학자들이 매달리게 됩니다. 이에 관한 연구는 소련뿐만 아니라 세계 각국에서 대대적으로 시작되게 됩니다. 적당한 미생물을 찾아서 그 미생물의 먹이가 되는 값싸고 입수가 용이한 석유 분류물을 찾아내기에 이르죠. 그리고 그 미생물의 품종을 개량하여 단백질 생산성이 뛰어난 미생물을 육종하게 됩니다. 그리고 이들 미생물이 성장할 때에 대사의 생화학적 및 생리학적인 특성을 연구해서 이를 기초로 해서 선발된 미생물을 증식시키는 방법을 개발하지 않으면 안되게 됩니다. 그렇기 때문에 이러한 미생물에 대한 연구는 대규모로 진행되었죠.

이어서 이러한 방식을 통해서 얻어진 단백질을 전면적으로 조사하지 않으면 안되는 상황이 되었습니다. 여러 가지 다양한 가축의 사료 속에 그 석유 단백질을 섞어서 사용하는 방법, 그 석유 단백질의 무해성과 영양가를 조사하고 이 석유 단백질을 사료로 해서 키운 소, 돼지, 닭을 원료로 해서 제조한 축산 가공품을 의학적, 생물학적으로 검사해서 미생물의 양과 질을 콘트롤하는 방법이 개발되게 됩니다.
그 결과는 어떻게 되었을까요?
우선 첫째로 과학자들은 어떤 특정한 미생물뿐만 아니라 많은 종류의 다를 미생물이 탄화수소를 먹고서 증식한다는 사실, 그런 미생물들이 토양(특히 유전지대의), 진흙, 물속등에서 생존한다는 사실을 밝혀내게 되었는데요. 또 석유의 탄화수소에서 잘 성장하고, 사료용 단백질을 생산하는데 적당한 효모의 균주를 품종개량과 유전학적 방법을 써서 얻어내는데 성공하기에 이르게 되었죠.

그리고 그것을 파라핀계 탄화수소를 증식시키는데 사용되었습니다. 과학자들은 생산된 단백질을 사료로 사용하는 방법을 개발하게 되는데요. 게다가 석유 단백질을 사료로 해서 키운 가축이나 가금류로 제조한 식품을 조사해서 그것이 양질의 것임을 밝혀내기도 했죠. 그 결과 석유의 파라핀 분류물에서 석유 단백질 사료를 생산하는 세계최초의 공장이 조업에 들어가는 계기를 마련했습니다.
현재 이 석유 단백질은 소련의 대다수 양계장에서 사용되고 있다고 합니다. 또 많은 축산 기업에서는 석유 단백질이 전체 단백질 함유량의 15% 혹은 그 이상이 함유된 사료를 가축에게 투여하고 있다는군요. 그 결과 가까운 장래에 연간 24만 톤의 생산능력을 갖춘 일련의 새로운 전문공장이 건설되게 되었습니다.
그러나 과학자들의 착상은 더욱더 전진하고 있었는데요. 석유는 미생물에게는 비교적 저렴한 먹이지만, 그것을 채취하여 분류하지 않으면 안되었던 것이죠. 그래서 대개의 경우 쓸데없이 태워버리든가, 아니면 대기 방출되어 버리는 석유가스를 이용해서 미생물을 증식시킬수는 없을까?를 고민하게 됩니다.
단백질의 50%는 탄소로 되어 있는데,메탄으로부터 이 탄소를 얻을수는 없을까?
메탄가스를 사용하여 미생물을 증식시키는 이 시험은 오랫동안 성공하지 못했었습니다. 그 이유는 이런 먹이를 좋아하는 미생물은 순수 배양해서 그 성장에 적합한 조건을 조성하는 것이 불가능했기 때문인데요. 미생물학자들은 몇 년 동안 이 문제에 몰두해서 악전고투한 결과 마침내 메탄가스를 산화하는 미생물의 균주를 순수 배양하는데에 성공했습니다.

이상에서 기술한 것 이외에 현대의 미생물학은 필요한 양의 사료용 단백질을 생산하기 위해서 이미 시험이 끝난 몇 가지의 방법을 갖고 있다고 할 수 있습니다. 다가올 다음 시대는 미생물 공업의 시대가 될 것이라 할 수 있는데요. 미생물을 이용하여 합성시킨 사료를 가축에게 합리적으로 투여하는 일이 가능하다면 축산업의 생산성과 경제성을 단기간에 향상시키는데 도움이 될게 틀림없다고 생각할 수 있는 부분이죠.
댓글 영역